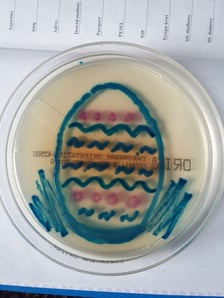
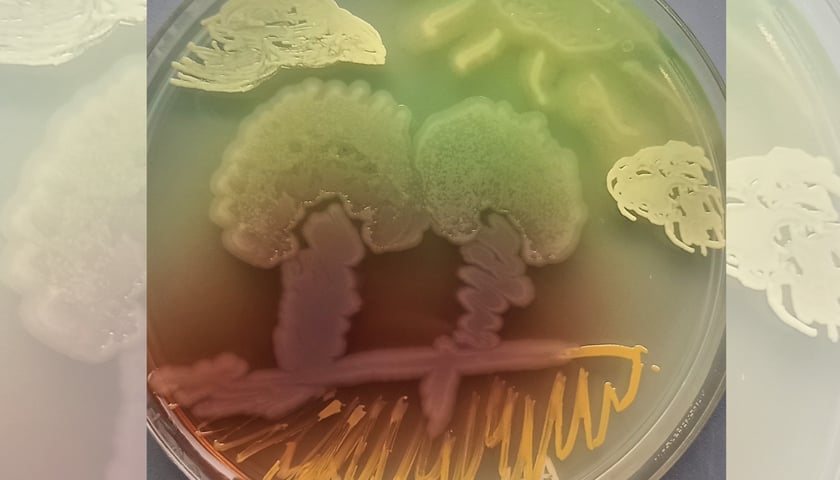

Najważniejsze informacje (kliknij, aby przejść)
A gdyby tak Picasso malował bakteriami...? Brzmi nieco abstrakcyjnie, trochę niewiarygodnie, a może nawet niebezpiecznie! A jednak. Picasso się na to nie zdobył, ale członkowie Studenckiego Koła Naukowego Mikrobiologii Farmaceutycznej już tak. I jeszcze zachęcają do tego innych!
Kurs „Zamiast farb – bakterie” na aukcji 32. Finału WOŚP
To czysta nauka, sam konkret, a pod okiem gr Karolina Dydak z Katedry i Zakładu Mikrobiologii Farmaceutycznej i Parazytologii Uniwersytetu Medycznego i studenci ze wspomnianego koła naukowego – nawet nie grozi zakażeniem.
Wylicytowany na aukcji WOŚP kurs odbędzie się w jednym z laboratoriów Uniwersytetu Medycznego w uzgodnionym terminie. Będzie się składał z trzech części:
- teoretycznej, obejmującej wiedzę o bakteriach, ich morfologii i podłożach, na których rosną;
- pokazowej, z oglądaniem bakterii pod mikroskopem;
- praktycznej, czyli zajęcia artystyczne.
Zwycięzca na 60-minutowy kurs malowania będzie mógł zaprosić jeszcze cztery osoby. Licytacja trwa TUTAJ. Cena pod młotkiem to 207,50 złotych (stan na 20 stycznia).
Ezy i wymazówki w dłoń!
Uczestnicy dostaną swoją sztalugę, czyli szklaną szalkę (inaczej płytkę Petriego) o średnicy około 30 centymetrów. Płótnem w tym przypadku będzie bezbarwne galaretowate podłoże.
– Podłoże jest bardzo delikatne i jeśli się za mocno na nie naciśnie, może pęknąć. Dlatego przygotujemy więcej płytek – mówi Klaudia Borkowska, przewodnicząca Studenckiego Koła Naukowego Mikrobiologii Farmaceutycznej.
Za pędzle artystom posłużą wymazówki (podobne do tych, którymi robi się testy covidowe) lub ezy (patyczki zakończone oczkiem). Od narzędzia zależeć będzie grubość kreski.
Przygotuj projekt albo zaufaj przypadkowi
Trzeba to wyraźnie powiedzieć: artyści będą malowali bezbarwnymi bakteriami na bezbarwnym podłożu. Może, choć oczywiście nie musi, wiązać się to z pewną nieprzewidywalnością co do ostatecznego efektu. Dlatego organizatorzy zalecają jedną z dwóch techniki: pełen spontan lub planowanie.
– Ja po prostu siadam i maluję! – Mówi Karolina Dydak. – Klaudia podchodzi do tego bardziej profesjonalnie…
– Przygotowuję projekt i podkładam go pod szalkę. Dzięki temu wiem, gdzie mam malować – wyjaśnia Klaudia Borkowska.
Niezależnie od metody i tak należy wykazać się elastycznością. Niektóre bakterie są bowiem bardziej ruchliwe i rozrastają się w grubszą linię. Dlatego z bakterii, jak zapewnia Karolina Dydak, najlepiej malować duże obiekty: kwiaty, owoce, drzewa, domy, zwierzęta.
Kolorowe bakterie na dłoniach noszę…
Każda kolonia bakterii ma swój kolor, zapach i charakterystyczną fakturę. Niektóre bakterie pachną jak jaśmin, inne jak zgniłe jajko.
– Większość bakterii, które udostępnimy, pozyskaliśmy podczas badań próbek z ostatniej edycji Dolnośląskiego Festiwalu Nauki – mówi Klaudia Borkowska. – Robiliśmy wówczas odciski dłoni lub innych przedmiotów i sprawdzaliśmy, co nam wyrośnie na podłożu. Są też bakterie, które sami nieświadomie „przynieśliśmy” do laboratorium i wyhodowaliśmy. Tak wzbogacamy naszą bazę bakterii.
Na pytanie, jakie bakterie będą w palecie, Karolina Dydak odpowiada:
– Udostępnimy Micrococcus. To bakteria, która barwi się na słoneczny żółty kolor.
Po chwili Karolina Dydak zapewnia, że Micrococcus nie jest groźna:
– To jest bakteria, która żyje na skórze i pomaga nam bronić się przed patogenami. Jeśli powoduje zakażenie, to tylko w skrajnych przypadkach obniżonej odporności i po bezpośrednim zawleczeniu jej na przykład do rany.
Dla artystów dostępny też będzie gronkowiec złocisty (łac. Staphylococcus aureus):
– Jak sama nazwa wskazuje, gronkowiec złocisty zazwyczaj jest złocisty, ale faktyczny odcień zależy od szczepu. Może być szary, żółty, a czasami wręcz pomarańczowy – mówi Karolina Dydak.
Na palecie malarskiej będzie też Pseudomonas. Bakteria ta została odkryta w XIX wieku w ranach żołnierzy walczących na wojnie. Badaczy zaintrygowały bandaże zabarwione na kolor zielono-niebieski, zbadali je i tak odkryli Pseudomonas.
– W laboratorium dysponujemy bakteriami Pseudomonas w kolorach od jadowicie żółto-zielonego, przez różne odcienie zielonego. Jest też szczep w kolorze brązowym – mówi Karolina Dydak.
Bakteria ta charakteryzuje się słodkawym zapachem… Niektórzy mówią, że pachnie jak jaśmin, inni że jak miód.
Dzięki gronkowcowi skórnemu będzie też dostępny kolor biały, a dzięki innym ziarenkowcom – czerwony.
– Ziarniak Gram-dodatni, którym dysponujemy, wyrasta w lodówce po około dwóch tygodniach na bardzo intensywny czerwony kolor. Jeśli więc ktoś go wybierze, będzie musiał dłużej poczekać na obraz – ostrzega Karolina Dydak.
Bezpieczeństwo przede wszystkim
Cały proces malowania jest bezpieczny, jeśli przestrzegane będą odpowiednie zasady.
– Dopóki bakteria nie dostanie się do organizmu przez błony śluzowe albo ranę, to nie ma niebezpieczeństwa zakażenia. Bakteria na płytce nic nam nie zrobi – zapewnia Klaudia Borkowska.
Ale i tak podczas malowania należy zachować jak największą ostrożność, nie poprawiać włosów, nie drapać się po nosie.
Lepiej też nie mówić zbyt wiele, bo na płytce mogą spaść ziarenkowce obecne w naszej ślinie. I choć tworzą eleganckie krople, to przecież mogą nie wpisać się w projekt.
W oczekiwaniu, aż bakterie się namnożą
Gdy już obraz będzie gotowy, zostanie przeniesiony do cieplarki. Tam, w temperaturze 37 stopni Celsjusza, bakterie będą miały najlepsze warunki do wzrostu.
– Każdy szczep ma swój czas potrzebny, aby wyrosnąć – mówi Klaudia Borkowska.
Zwycięzca nie dostanie jednak płytek z bakteriami. Obraz zostanie sfotografowany i przesłany uczestnikom kursu w postaci zdjęć, a „płótno” – zutylizowane.